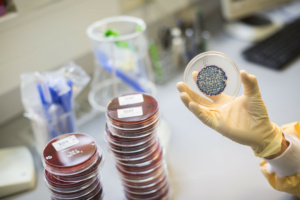

Das Wochenende, 7./8. September 2024: Autobrände, Unfall auf A14 und Tag des offenen Denkmals
In der Nacht zu Samstag brannten in Leipzig wieder mehrere Wagen aus, unter anderem in Lindenthal. Bei einem größeren Unfall am Samstag wurden auf der A14 bei Schkeuditz mehrere Personen verletzt. Und: Unter dem Motto „Wahr-Zeichen. Zeitzeugen der Geschichte“ konnten am Sonntag zum Tag des offenen Denkmals wieder zahlreiche, spannende Orte besichtigt werden. Die LZ […]

Aktuelle Kommentare